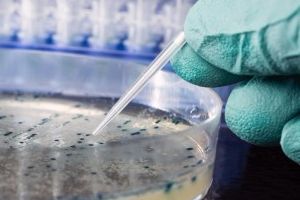
Лабораторное исследование Лабораторное исследование

Кишечная палочка в мазке у мужчин выявляется редко. Данный микроорганизм проживает в нижнем отделе толстого кишечника. Патологическими они не являются. В организме здорового человека данное расположение палочки не считается негативным. Проблемы обнаруживаются при ее переселении в различные органы и ткани. Необходимо разобрать причины такой локализации и возможные осложнения, которые могут возникнуть.
Причины распространения инфекции
Кишечная палочка не может переселиться самостоятельно. Существуют разнообразные негативные факторы, вызывающие изменение ее расположения. Выделяются следующие причины инфицирования тканей палочкой:
- несоблюдение правил интимного ухода;
- употребление немытых продуктов;
- заселение палочки через загрязненную воду;
- незащищенный анальный секс;
- тактильный контакт с носителем.
Основной причиной поражения слизистых тканей является несоблюдение правил интимного ухода. Современная косметическая индустрия разработала большое количество различных средств для соблюдения личной гигиены. Врачи разработали ряд правил. Но не всегда мужчина выполняет данные правила. Несвоевременное очищение половых органов сопровождается развитием и размножением патогенной микрофлоры. Постепенно происходит гибель полезной микрофлоры. Освободившееся место занимают разнообразные бактерии. Анальное отверстие располагается в непосредственной близости к гениталиям. Это приводит к распределению кишечной палочки по слизистой уретрального канала.
Причиной инфицирования может стать и употребление в пищу загрязненных продуктов. Немытые фрукты, ягоды и овощи могут содержать на своей поверхности опасные микроорганизмы. Палочка способна выживать при температуре окружающей среды до 60 градусов. Если продукты не подвергаются обработке, происходит сохранение патогенной микрофлоры. Бактерии попадают в желудочно-кишечный тракт. С этого момента палочка начинает активно размножаться. В различных анализах выявляется кишечная бактерия.
Врачи отмечают, что энтерококки, являющиеся частью нормальной микрофлоры кишечника, могут вызывать инфекции в мужской мочеполовой системе. Особенно это касается случаев, когда иммунная система ослаблена или нарушена микрофлора. Специалисты подчеркивают, что такие инфекции могут проявляться в виде уретрита, цистита или простатита. Симптомы часто включают болезненное мочеиспускание, частые позывы и дискомфорт в области таза. Важно отметить, что диагностика требует комплексного подхода, включая анализы мочи и, при необходимости, посевы. Врачи рекомендуют не игнорировать симптомы и обращаться за медицинской помощью, чтобы избежать осложнений и обеспечить своевременное лечение.

Другие факторы

Наиболее распространенной причиной попадания кишечной палочки в уретральный канал является незащищенный сексуальный контакт. Небольшое количество микрофлоры кишечника партнера попадает в верхнюю часть мочеиспускательного канала. Не всегда промывка половых органов может помочь устранить болезнетворный микроорганизм. Чтобы предотвратить такой путь заражения, следует использовать презерватив при анальном контакте.
Болезнь диагностируется и после тактильного контакта с носителем кишечной палочки. На кожных покровах всегда присутствуют незаметные для глаз повреждения. Через ранки палочка быстро проникает в организм. Чтобы избежать проблем, следует после любого контакта с людьми очищать руки специальными антибактериальными средствами.
Симптоматика патологического инфицирования
Кишечная палочка обнаруживается в организме после прохождения инкубационного периода. Длительность ее распространения небольшая. Первые признаки инфицирования обнаруживаются через двое суток после заражения. Реже данный период более длительный. Такое явление наблюдается у мужчин с хорошей иммунной защитой.
После заражения могут наблюдаться различные симптомы, схожие с острым респираторным заболеванием. Мужчина жалуется на появление следующих признаков заражения:
- повышение температурных показателей;
- развитие слабости;
- болезненность в различных отделах брюшной зоны.
Первым признаком поражения слизистой уретры является резкое повышение температуры тела. Результаты замеров могут достигать 39 градусов. Такие показатели держатся в течение нескольких дней. Многие пациенты ошибочно принимают данный симптом за признак ОРВИ. Это приводит к неправильному подбору лечения и развитию сильного инфицирования.

Также выявляется болезненность в различных частях брюшины. Локализация болевого синдрома зависит от органа, который заражен кишечной палочкой. Размножение микроорганизма сопровождается расширением зоны болезненности. Пальпация позволяет установить незначительное уплотнение в пораженном участке.
После общих признаков развиваются специфические симптомы. Для инфицирования кишечной палочкой характерно появление диспепсических явлений. В течение суток мужчина несколько раз вынужден посещать туалет для опорожнения кишечника. Кал становится менее плотным. В нем обнаруживается слизь. Массы могут иметь жидкую структуру. Человек жалуется, что стул похож на воду.
Наблюдается сильная рвота. Рвотные массы имеют зеленоватые включения. Выделяемая жидкость сильно пенится. Во рту появляется гнилостный привкус. Длительная рвота и диарея сопровождается быстрым обезвоживанием организма. При появлении этих симптомов мужчине необходима срочная медицинская помощь.
Энтерококки — это группа бактерий, которые обычно обитают в кишечнике человека, но их присутствие в мочеполовой системе может вызывать определенные опасения. Многие мужчины отмечают, что обнаружение энтерококков в анализах мочи вызывает у них беспокойство, так как это может свидетельствовать о наличии инфекции. Врачи подчеркивают, что эти бактерии могут быть частью нормальной микрофлоры, но их избыточное количество может привести к воспалительным процессам, таким как уретрит или цистит. Некоторые пациенты сообщают о симптомах, таких как жжение при мочеиспускании или частые позывы, что заставляет их обращаться за медицинской помощью. Важно отметить, что правильная диагностика и лечение могут помочь избежать осложнений. В целом, отношение к энтерококкам в мужской мочеполовой системе варьируется от беспокойства до понимания их роли в организме, что подчеркивает необходимость информированности и консультаций со специалистами.

Характеристики болезнетворного микроорганизма
Палочка является важным составляющим микрофлоры толстого кишечника. Она выполняет много полезных функций.
При поступлении в тракт пищи начинается активная работа микрофлоры. Микроорганизмы участвуют в расщеплении пищи и усвоении витаминно-минеральных веществ. Кишечная палочка помогает организму получить такой микроэлемент, как витамин К. Также она устраняет продукты распада и участвует в формировании каловых масс.
Выделяется большое количество разновидностей кишечных палочек. Они относятся к эшерихиевому роду. Данный род включает более 100 видов микроорганизмов. Особенностью эшерихий является способность прочно закрепляться на плоском эпителии разнообразных органов. Именно по этой причине кишечная палочка часто обнаруживается в полости мочевого пузыря и мочеиспускательной системе. Благодаря плотному закреплению палочка не покидает полость пузыря в процессе опорожнения. Количество болезнетворных бактерий сохраняется на постоянном уровне.
Осложнения при инфицировании

- сепсис;
- язва желудка и прободение тканей;
- мочекаменная болезнь;
- эректильная дисфункция;
- бесплодие различной этиологии.
Одним из опасных осложнений является сепсис. Это заболевание характеризуется распространением болезнетворных микробов по кровотоку. Появляется сильное воспаление сосудистой системы. При сепсисе необходимо срочное очищение кровяной жидкости. Незначительное промедление может привести к летальному исходу.
Кишечная палочка вызывает изменение свойств тканей. Распространение бактерии по стенке желудка приводит к гибели полезной микрофлоры. Патогенные микробы питаются клетками тканей. Длительное пребывание микроба на стенке желудка приводит к язвенной болезни. Более тяжелой проблемой при инфицировании является прободение. Данная проблема сопровождается появлением отверстия в стенке желудка. Остатки пищи попадают в брюшную полость. При таком осложнении мужчина нуждается в срочном хирургическом вмешательстве.
Появление микроорганизма в мочеполовой системе может вызвать негативные процессы в почечных лоханках. Бактериальное заражение вызывает нарушение работы данного органа. Почки выполняют всасывательную функцию. Под воздействием специального слоя различные полезные микроэлементы всасываются в кровоток. Вредоносные же вещества выводятся с мочой в пузырь. При мочеиспускании часть вредных веществ скапливается в нижнем отделе пузыря. Образуются хлопья. Более опасной формой осложнения является мочекаменная болезнь.
Опасность патологии
Для мужчины патология опасна различными осложнениями со стороны половой системы. Распространение недуга по мочеполовому каналу приводит к инфицированию предстательной железы. Простата отвечает за поддержание уровня тестостерона и выработку основы эякулята. Развитие болезни в одной из долей предстательной железы вызывает воспаление всего органа. При этом происходит снижение выполнения основных обязанностей органа. Тестостерон помогает усилить работу гипофиза. Продуцирование вещества сопровождается появлением импульса. Передача сигнала воздействует на нервные окончания пениса. Происходит раздражение мышечной ткани. Усиление эластичности вызывает приток крови к пещеристым телам. Пенис наполняется кровяной жидкостью. Возникает эрекция. Бактериальное заболевание сопровождается нарушением гормонального уровня. Данные явления воздействия влекут изменение эректильной функции. У мужчины пропадает половое возбуждение или оно становится непостоянным.
Именно по этим причинам заражение уретрального канала необходимо своевременно лечить.
Диагностирование проблемы
Определить локализацию и вид патогенного организма можно с помощью взятия пробы со слизистой уретры. Мазок берется с помощью специального медицинского шпателя. Проба помещается в емкость с жидкостью и направляется в лабораторию. Изучение возможно только после выполнения пациентом ряда правил. Перед взятием мазка необходимо соблюдать следующие условия:
- избегать сексуальных контактов;
- соблюдать специальную диету;
- отказ от антибактериальных средств для интимного ухода.
Все эти условия помогут сохранить состав микрофлоры. После исследования необходимо также сдать пробу мочи. Забор жидкости осуществляется через катетер. Он вводится в полость мочевого пузыря через уретральный канал. Это позволяет совершить полноценное изучение жидкости.
Также необходимо исследовать мазок на чувствительность к различным антибиотическим лекарственным средствам. Для этого выращенная колония кишечных палочек помещается в несколько чашек. В каждую емкость вводится небольшое количество раствора с антибиотиком. После небольшого количества времени специалист изучает состояние микроорганизмов. Препарат, который убил большее количество микроорганизмов, будет использоваться в качестве основного лечебного средства.
Терапевтическое воздействие
Лечение мужчины от заражения кишечной палочкой осуществляется несколькими фармакологическими средствами. Для терапии используются следующие группы: антибиотические, противомикробные, бактериологические, адсорбирующие.

Современные врачи часто используют импортный доксициклин — Юнидокс Солютаб. Данная форма выпускается в виде диспергируемых таблеток. Они полностью растворяются в воде и не всасываются в желудке. Такая форма способствует избежанию получения осложнений со стороны желудка. Усвоение препарата происходит в кишечнике. Дозировка и частота применения подбирается лечащим врачом.
При уретральном инфицировании хороший эффект оказывают препараты, созданные на основе бактериофагов. Бактериофаги являются врагами разнообразных патогенных микроорганизмов. Для устранения кишечной палочки используется стафилококковый бактериофаг. Он выпускается в виде лиофилизированного порошка. Часть порошка разводится водой для инъекции. Полученный раствор вводится с помощью катетера в мочевой пузырь. При низком расположении инфекции раствор используется в виде спринцевания. Терапия осуществляется с периодическим изучением мазка из мочеиспускательного канала. При очищении мазка от палочки бактериофаг прекращают использовать.
Чтобы полностью устранить распространение палочки необходимо использовать адсорбирующие препараты. Они помогают устранить продукты жизнедеятельности болезнетворных микробов. Если такие лекарственные средства не используются, возможно развитие сильной интоксикации. Избежать отравление можно и с помощью энтеробиотиков. Они вводятся в виде жидкости. Принимать такие лекарственные средства следует до полного очищения мазка.
Профилактические меры
Чтобы избежать появление палочки в мазке следует соблюдать определенные правила. Пациент должен тщательно следить за соблюдением интимного ухода. После посещения туалета необходимо промывать половые органы под теплой проточной водой.
Посещение открытых водоемов должно осуществляться только в специально отведенных местах. Дикие пляжи посещать не рекомендуется.
Также необходимо использовать при половом контакте. Он поможет предотвратить попадание кишечной микрофлоры в уретру. После контакта нужно принять душ с моющим средством.
Не рекомендуется носить тесное и обтягивающее нательное белье. Такое белье приводит к прямому контакты анального отверстия с тканью. Часть микрофлоры кишечника легко попадает в мочеиспускательный канал.

Соблюдение всех этих правил поможет избежать неприятной проблемы. Если же по каким-либо причинам заражение кишечной палочкой произошло, необходимо незамедлительно посетить врача. Только специалист может изучить состав мазка и подобрать эффективное лечение.
Вопрос-ответ
Что такое Enterococcus faecalis у мужчин?
Энтерококк фекальный (Enterococcus faecalis) — наиболее часто встречающаяся в организме бактерия рода энтерококков, представляющая нормальную микрофлору желудочно-кишечного тракта человека и некоторых млекопитающих.
Как лечить энтерококковую инфекцию мочевыводящих путей?
Амоксициллин является препаратом выбора для лечения энтерококковых инфекций мочевыводящих путей. Терапия второй линии включает ванкомицин и нитрофурантоин. Альтернативные методы лечения включают даптомицин и линезолид, однако эти новые препараты в идеале следует резервировать для более серьёзных инфекций, чтобы сохранить активность возбудителя.
Как лечить Enterococcus faecalis в моче?
Для лечения острых неосложненных инфекций мочевыводящих путей, вызванных Enterococcus faecalis, могут быть рекомендованы нитрофураны, цефалоспорины III поколения, гентамицин, фторхинолоны, последние — с оговоркой о неблагоприятных тенденциях к росту устойчивости.
Где можно заразиться энтерококком?
Энтерококк можно заразиться в различных местах, включая больницы, где он может передаваться через контакт с инфицированными пациентами или медицинскими инструментами. Также риск заражения существует в общественных местах, где наблюдается плохая гигиена, например, в туалетах или на кухнях. Кроме того, энтерококки могут находиться в загрязненной воде и пище, особенно в сыром или недостаточно термически обработанном мясе и молочных продуктах.
Советы
СОВЕТ №1
Регулярно проходите медицинские обследования, особенно если у вас есть предрасположенность к инфекциям мочеполовой системы. Это поможет выявить проблемы на ранних стадиях и предотвратить развитие серьезных заболеваний.
СОВЕТ №2
Обратите внимание на личную гигиену. Поддержание чистоты в области половых органов и соблюдение правил гигиены могут значительно снизить риск заражения энтерококками и другими патогенными микроорганизмами.
СОВЕТ №3
Следите за своим питанием и образом жизни. Здоровая диета, регулярные физические нагрузки и отказ от вредных привычек укрепляют иммунную систему, что помогает организму бороться с инфекциями.
СОВЕТ №4
При появлении симптомов, таких как боль при мочеиспускании, частые позывы или дискомфорт в области таза, не откладывайте визит к врачу. Раннее обращение за медицинской помощью может предотвратить осложнения и ускорить процесс выздоровления.
